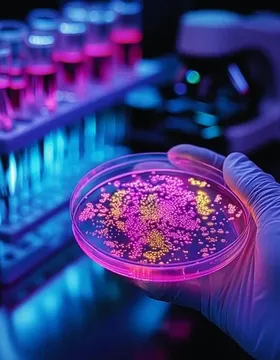
Improve your language skills with science articles and educational videos

The LingQ Method
You’ve tried traditional methods and gamified drilling apps. Now try our natural, immersive approach; backed by science, designed for the way the brain learns.
Get started for free!Immerse yourself in real-world content
No more boring lessons and drills. Learn languages enjoyably while listening to podcasts, reading books, watching TV shows and more.
Get started for free!

Dramatically grow your vocabulary
Encountering words naturally in meaningful contexts will lead to massive vocabulary growth, the only way to truly succeed in your new language.
Get started for free!Real progress that you can see and feel
Everything you do on LingQ is measured. See the effort you are making and track your exponential growth. Celebrate each milestone along the way.
Get started for free!

Powered by AI
Found a great show on Netflix, or a new song you love? Instantly turn it into a lesson with LingQ’s AI tools—transcripts, translations, audio and more.
Get started for free!Endless content. Unlimited learning.
Choose a lesson from our massive library or import any content you find.
Learn from what you're interested in - movies, podcasts, books, videos.
Books
Podcasts
Netflix
Tiktok
Songs
YouTube
YouTube Shorts
Spotify
Apple TV
Articles
Disney +
Amazon Prime
Get the LingQ Importer extension for your browser
Turn your favorite content into interactive lessons with just one click. Learn more about how it works.
Join over 5 million learners worldwide
Connect with a vibrant community of happy, active learners and start improving your language skills today.

Maria
Words learned:
19178

Daniel
Words learned:
39174
98767

Sophia
Words learned:
2917
38876
1267

David
Words learned:
19178
3883
1267
964

Isabella
Words learned:
2341
5571
442

James
Words learned:
1634
7726

Antonio
Words learned:
5342
4.7 average rating on App Store and Google Play
What LingQers are saying
LingQ is my favourite online resource for language learning. Their gigantic library in different languages gives me the opportunity to build vocabulary with great material that includes audio and text.

Gabriel Silva
I really want to thank LingQ so much for transforming the way I learn languages. By highlighting words and phrases, your vocabulary and grammar knowledge improves naturally as you read.

Simon Haisell
I decided to sit the DELF B1 exam after a year of using LingQ, but I was not expecting so much success. I got 90 which was the highest among all the students who took the test!

Aaya Al Kawaz
🙌🏻 LingQ is amazing. If you spend an hour or so figuring out how you can manage playlists, import material, etc., it becomes your goldmine of content in your pocket. I love how you can see how much of a new article/lesson you’ve never come across before too.

Tom
"All you need is the desire to communicate and the right system, the LingQ System!"

Steve Kaufmann
World renowned polyglot, speaker of 20 languages, co-founder of LingQ
Get started for free!Frequently Asked Questions
Get your questions answered
Learn a language the natural way
Read, listen, and learn from real-world content,and achieve fluency faster with LingQ!
Get started for free!